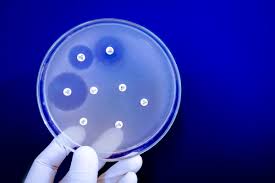

¡Encuentra a tu médico o especialista!
¿Buscas algún tema en específico?
Visita nuestro foro, realiza preguntas a los especialistas y ve otras dudas que han sido resueltas.
Jalisco busca concientización sobre resistencia antimicrobiana
La Secretaría de Salud Jalisco (SSJ), en coordinación con la Comisión para la Protección Contra Riesgos Sanitarios del Estado de Jalisco (Coprisjal), llevó a cabo la Primera Carrera Recreativa-Atlética de la Farmacovigilancia y Tecnovigilancia en el Parque Metropolitano.
Te recomendamos: ¿Cómo saber que tomé mucho café? 12 señalas de exceso
Jalisco busca concientización sobre resistencia antimicrobiana
Esta iniciativa se realizó a fin de integrar la actividad física con la cultura de la prevención sanitaria, en el marco de la Semana Mundial de la Concientización sobre la Resistencia a los Antimicrobianos, en la que se difunden mensajes clave sobre el riesgo que representa el mal uso y abuso de antibióticos, antivirales y antifúngicos, así como la importancia de reportar el desempeño de los dispositivos médicos.
José Antonio Muñoz Serrano, Comisionado de la Coprisjal, destacó que la importancia de la vigilancia farmacológica y tecnovigilancia e invitó a la ciudadanía a asistir al médico antes de tomar algún medicamento y señaló:
“Buscamos con esta carrera, vincular el deporte con la vigilancia farmacovigilancia y Tecnovigilancia, es muy importante que la gente lo sepa, tenemos que estar siempre al pendiente de las reacciones adversas de los medicamentos y con esto queremos llamar la atención de la sociedad, invitarlos para que ellos hagan uso de esta herramienta, que puedan ir con su médico”.
El funcionario aseguró que de esta forma se puede tener el parámetro para saber si es necesario hacer modificaciones en los medicamentos.
La justa convocó a corredoras, corredores y familias quienes participaron en las rutas de 3 y 5 kilómetros tras una sesión de calentamiento y rendir honores a la bandera. El encuentro fungió como plataforma para visibilizar que la salud pública es una responsabilidad compartida.
Una carrera contra la resistencia antimicrobiana
La actividad física reunió a 520 personas, quienes, además de promover la actividad física, reconocieron que los hábitos saludables y el uso responsable de medicamentos es fundamental para la salud.
El evento concluyó con la premiación y entrega de reconocimientos, fortaleciendo este esfuerzo institucional y la participación social activa como eje clave para la salud pública.
En la categoría varonil de 3 kilómetros, el primer lugar fue para Argel Gómez, seguido de Iván Lara y Yojan Salas en segundo y tercer lugar respectivamente. En la categoría femenil, Mayra Villaseñor fue la primera en llegar a la meta, Fátima Espinoza llegó en segundo lugar y Julia González en tercero.
En tanto, la ruta de 5 kilómetros en la rama varonil el ganador fue Julio César Navarro, quien fue acompañado por Carlo Aldama, en segundo lugar, y Jesús Antonio Sánchez, en tercer lugar. En la categoría femenil la ganadora fue Yaretzi Godínez, en el segundo lugar llegó Yazmín Sánchez y en tercero Mayra Castillón.

Conoce más de la resistencia antimicrobiana
La resistencia a los antibióticos es un problema mundial que crece. Lo anterior ha llevado a que muchos gobiernos pidan a los médicos veterinarios que restrinjan su uso en los animales, por lo que consideró importante que en México se tomen acciones que mejoren la capacidad de esos profesionales para hacerse responsables de contener el uso de antimicrobianos.
La resistencia a los antimicrobianos (RAM) surge cuando las bacterias, los virus, los hongos y los parásitos cambian a lo largo del tiempo y dejan de responder a los medicamentos, lo que hace más difícil el tratamiento de las infecciones e incrementa el riesgo de propagación de enfermedades, de aparición de formas graves de enfermedades y de muerte.
Como consecuencia de la farmacorresistencia, los antibióticos y otros medicamentos antimicrobianos se vuelven ineficaces, por lo que las infecciones son cada vez más difíciles o imposibles de tratar.
Te recomendamos: Mucho cansancio puede ser señal de estas enfermedades
Finalmente, como parte de las acciones permanentes de la Coprisjal, se impulsan labores de fomento, investigación y prevención de riesgos sanitarios en Jalisco, por lo que durante el evento se entregaron insumos y material informativo sobre el uso de medicamentos y antibióticos.
¿Alguna duda con respecto al tema?
¡Pregúntale al experto!Presentan “Lentejas Bienestar”: ¿qué son las leguminosas?
COFEPRIS y el INSP firman convenio en materia de investigación, capacitación y cooperación
Lo más leído
Comentarios
No hay comentarios aún.
